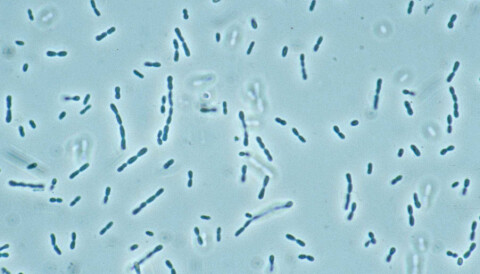

Greenhouse Gases Articles

Rising Emissions Drive Greenhouse Gas Index Increase

Greenhouse Gases News Research And Analysis The

Greenhouse Effect Encyclopedia Article Citizendium

Bacteria That Eat Greenhouse Gases
Climate Change Electrical Industry S Dirty Secret Is Only

Bridging The Greenhouse Gas Emissions Gap Nature Climate

Sucking Up Carbon Greenhouse Gases Must Be Scrubbed From

Asia Times China Aims To Capture Greenhouse Gases Article

Growing Blanket Of Carbon Dioxide Raises Earth S Temperature

Co2 Emissions Guidelines Under The Energy Lawsperspectives
Tidak ada komentar untuk "Greenhouse Gases Articles"
Posting Komentar